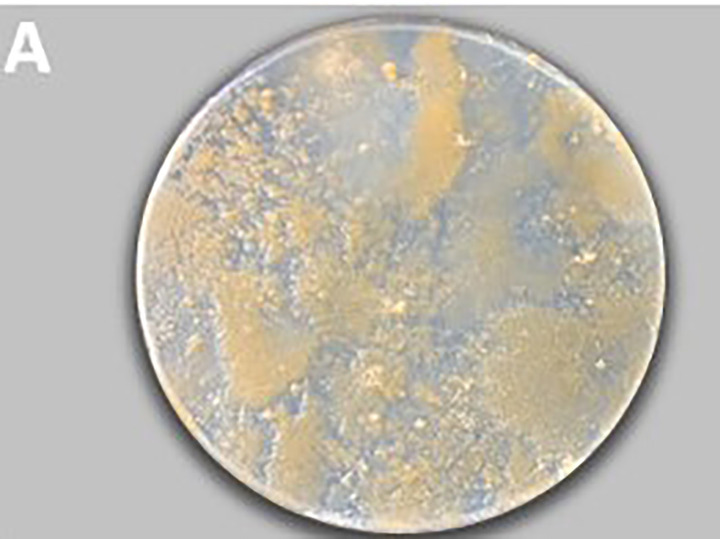

Разрушающий гриб обнаружили на древней иконе из Третьяковской галереи ученые ФИЦ Биотехнологии РАН
Необычный гриб, разрушающий произведение искусства, обнаружили на новгородской иконе XVI века «Деисус из 13 фигур» ученые ФИЦ Биотехнологии РАН. Они изучили биоразрушающий потенциал микроорганизма и ищут сейчас способ защитить икону. Результаты исследования, о котором сообщили в РНФ, опубликованы в журнале Journal of Cultural Heritage.
 Образцы с иконы «Деисусный чин 13-фигурный»: четыре фрагмента (увеличенные), обозначенные зелеными точками, имели потеки и сколы краски, свидетельствующие о совместном развитии грибков и бактерий. Источник: Journal of Cultural Heritage
Образцы с иконы «Деисусный чин 13-фигурный»: четыре фрагмента (увеличенные), обозначенные зелеными точками, имели потеки и сколы краски, свидетельствующие о совместном развитии грибков и бактерий. Источник: Journal of Cultural Heritage
Деисус (от греч. δέησις — прошение, моление) — икона имеющая в центре изображение Христа, а справа и слева от него соответственно — Богоматери и Иоанна Крестителя. Также может включать аналогичные изображения апостолов, святых отцов, мучеников. Основной догматический смысл деисусной композиции — посредническая молитва, заступничество за род людской перед лицом грозного Небесного Царя и Судии.
Сотрудники группы генетической инженерии грибов ФИЦ Биотехнологии РАН под руководством Александра Жгуна давно сотрудничает с Государственной Третьяковской галереей. «МК» писал об их работе в залах древнерусской живописи. Ученые исследовали тогда микробиологическое состояние икон «Благословенно воинство Небесного Царя» (1550-е годы), «Святой Великомученик Димитрий Солунский» XVI века, фрагмент скульптуры «Святой Великомученик Георгий Победоносец» 1464 года и другие.
Так выглядит под микроскопом штамм Iodophanus sp. STG-150. Источник: Journal of Cultural Heritage
Так выглядит под микроскопом штамм Iodophanus sp. STG-150. Источник: Journal of Cultural Heritage
В январе 2023 года ученые отобрали 15 микробиологических проб с поверхности двухметровой новгородской иконы XVI века «Деисус из 13 фигур» из коллекции историка и реставратора древнерусской живописи А.И. Анисимова (она попала в Третьяковку в 1930-х годах). Реставраторы обратились за помощью к биотехнологам, обеспокоившись появлением зон предполагаемого биоповреждения иконы.
Исследование показало, что на общем бактериальном фоне, присутствовавшем на ней, основным представителем грибов оказался Iodophanus sp. из семейства Pezizaceae (пецицевые). Ученых удивило его новое «место обитания», так как ранее считалось, что эти грибы в основном живут на разлагающейся листве.
Дальше исследователям надо было понять, насколько агрессивен выделенный штамм для старинного полотна. Для этого его высевали на специальные макеты, моделирующие темперный слой древней иконы с покрытием на основе красок, сделанных на основе старинных рецептов, таких, как яичная темпера, осетрового клея, защитных лаков и других компонентов.
Выяснилось, что активней всего штамм гриба Iodophanus sp. поражал именно яичную темперу, осетровый клей и пигмент охру, а вот, к примеру, красные, кобальтово-зеленые пигменты он поглощал в меньшей степени. Что касается цинковых белил, – если это вещество встречалось на пути распространения штамма, то этот процесс останавливался из-за токсичного действия белил на гриб.
 Графическая абстракция, иллюстрирующая предпочтения гриба Iodophanus sp. Источник: Journal of Cultural Heritage
Графическая абстракция, иллюстрирующая предпочтения гриба Iodophanus sp. Источник: Journal of Cultural Heritage
Выяснив, что «любит» и чего «боится» разрушающий икону грибной штамм, исследователи приступили к подбору «оружия» против него, а именно антисептиков. На данном этапе к работе присоединились специалисты Института молекулярной биологии им. В.Э. Энгельгардта РАН. Эффективней всего оказались новые, недавно синтезированные в ИМБ РАН серосодержащие соединения.
На следующем этапе работы ученым предстоит опробовать действие антисептиков непосредственно на живописных материалах. Это также будет проведено сначала на макетах. Лучшее соединение будет использовано для последующей обработки иконы «Деисус из 13 фигур».


















































Свежие комментарии